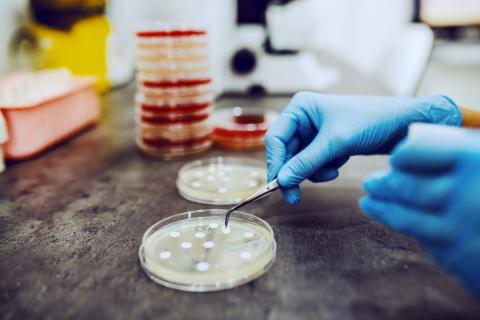
Petri dishes in a lab

Author profile
Karen MacDonell, PhD, MLIS
The CPS app from the Canadian Pharmacists Association and the Essential Evidence Plus app are no longer available from the Canadian Medical Association after closure of the CMA Library due to a change in the... Read More
Infectious diseases in the British Columbian population during 2022 have posed major challenges to the health system. Keeping abreast of emerging and persistent infectious diseases is crucial, and the following may be... Read More
As a type of information resource, BMJ Best Practice, DynaMed, and UpToDate have many names: point-of-care information tools, clinical decision support resources, electronic textbooks, and more. All are interactive... Read More
Libraries are normally quiet, and they have been even more so during the pandemic. The physical College Library is closed and staff are working mainly from home. However, the Library has had a virtual aspect even from... Read More
Health inequity arising from personal and systemic bias against Black people, Indigenous people, and people of color is a pressing issue in Canada, but resources for addressing this in Canadian medical practice are... Read More
Libraries’ physical footprints are getting smaller, but their collections are growing virtually. Books have made the transition to electronic formats much more slowly than journals, but e-books now account for a... Read More
Locating clinical practice guidelines can be challenging. Many are simply posted on the Internet rather than being published in scholarly journals; thus, they escape the notice of medical databases such as Medline.... Read More
Clinical practice guidelines are “statements that include recommendations intended to optimize patient care and are informed by a systematic review of evidence and an assessment of the benefits and harms of alternative... Read More
College of Physicians and Surgeons of BC Library services and resources are eligible for continuing professional development credits through the Royal College of Physicians and Surgeons of Canada (RCPSC) Maintenance of... Read More
The ClinicalKey mobile app for iOS and Android and the web-based version are available to all College registrants with Library access. ClinicalKey provides access to Elsevier’s extensive collection of medical journals,... Read More